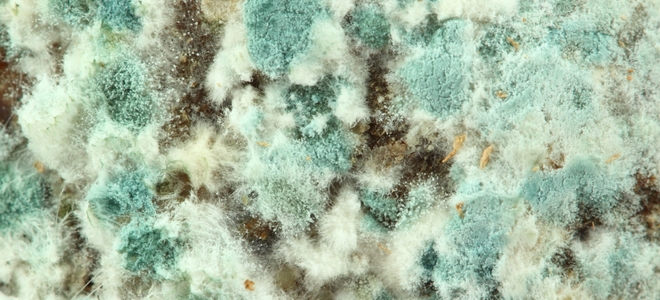
Elimine el moho y los hongos de su hogar

-

Eliminación de moho / hongos negros de grietas difíciles de alcanzar
El moho negro es la sustancia de color negro verdoso que se encuentra en la madera empapada, las tejas del techo, los paneles de las paredes, el cartón e incluso los artículos hechos de algodón. Este moho negro es causado por la humedad. Cuando toca físicamente una mancha de moho negro, se mancha y se…
-

Técnicas de eliminación de moho y hongos
Para el moho y hongos domésticos, existen técnicas de remediación para abordar el crecimiento de hongos. Las siguientes técnicas describen varios métodos para resolver sus problemas de moho y hongos. Paso 1: tome las precauciones de seguridad Para eliminar el moho y los hongos, es aconsejable tomar precauciones de seguridad. Ciertos ingredientes pueden desprender olores…
-

Consejos para prevenir el moho y los hongos en la cocina
La formación de moho y hongos es una ocurrencia común en lugares húmedos. En la mayoría de los hogares, la cocina y el baño proporcionan el entorno de cultivo perfecto para el moho y los hongos. Una vez que aparece este problema, es muy difícil eliminarlo por completo. Al prevenir el moho y los hongos…
-
Elimine el moho y los hongos de su hogar
El clima húmedo es un imán para el moho y el crecimiento de moho. La mejor manera de deshacerse del moho en su hogar es eliminar completamente cualquier moho o hongos tan pronto como sea posible para evitar cualquier posibilidad de manchas permanentes. Si bien el moho y el moho generalmente crecen en el baño…
-

Cómo quitar y prevenir el moho y los hongos en la madera
El moho y los hongos pueden ser peligrosos para las personas y dañinos para la madera, por lo que siempre es una buena idea limpiarlos cuando surjan. Mientras lo hace, aplicar una nueva capa de sellador puede evitar que el problema vuelva a aparecer. Paso 1: preparación Si está quitando moho y hongos de una…
-

8 causas de moho y hongos en la cocina
Es importante estudiar moho y hongos, cada uno de los cuales resulta ser un hongo que se encuentra fácilmente en cada parte de la naturaleza. En la naturaleza, pueden descomponer sustancias, pero también son una parte importante de las redes alimentarias. Sin embargo, en las cocinas suponen un problema importante por lo que vale la…
-

Eliminación de moho y hongos en el sótano: una guía
La eliminación de moho y hongos puede mejorar en gran medida la atmósfera dentro de una casa. Estos organismos son muy peligrosos para la salud si se dejan florecer en cualquier parte de la casa. Además, pueden contribuir al deterioro de las estructuras y los materiales de construcción. Estos organismos pueden crecer en cualquier lugar…
-

¿Qué causa el moho y los hongos en un baño?
Moho y hongos se encuentran entre los problemas más comunes en los baños domésticos y puede ser difícil deshacerse de ellos. Si alguno de los baños de su casa ha sido víctima recientemente de la formación de moho o hongos, es posible que sienta curiosidad por las posibles causas. A continuación, encontrará información sobre las…
-

Una guía para la eliminación de moho y hongos en alfombras
Si alguna de las áreas alfombradas de su hogar ha sido víctima de los depósitos de moho o hongos, debe familiarizarse con el método adecuado para eliminar el moho y los hongos a base de alfombras. Con una guía instructiva informativa a su disposición, las alfombras de su hogar pueden estar libres de moho y…
-

Eliminación y prevención de moho y hongos en el refrigerador
Si su refrigerador ha sido recientemente incendiado por una infestación de moho o hongos, es importante que conozca la forma adecuada de remediar este problema. Una vez que elimine con éxito el moho y / o hongos de su refrigerador, será beneficioso saber cómo prevenir este problema en el futuro. A continuación, se detallan las…